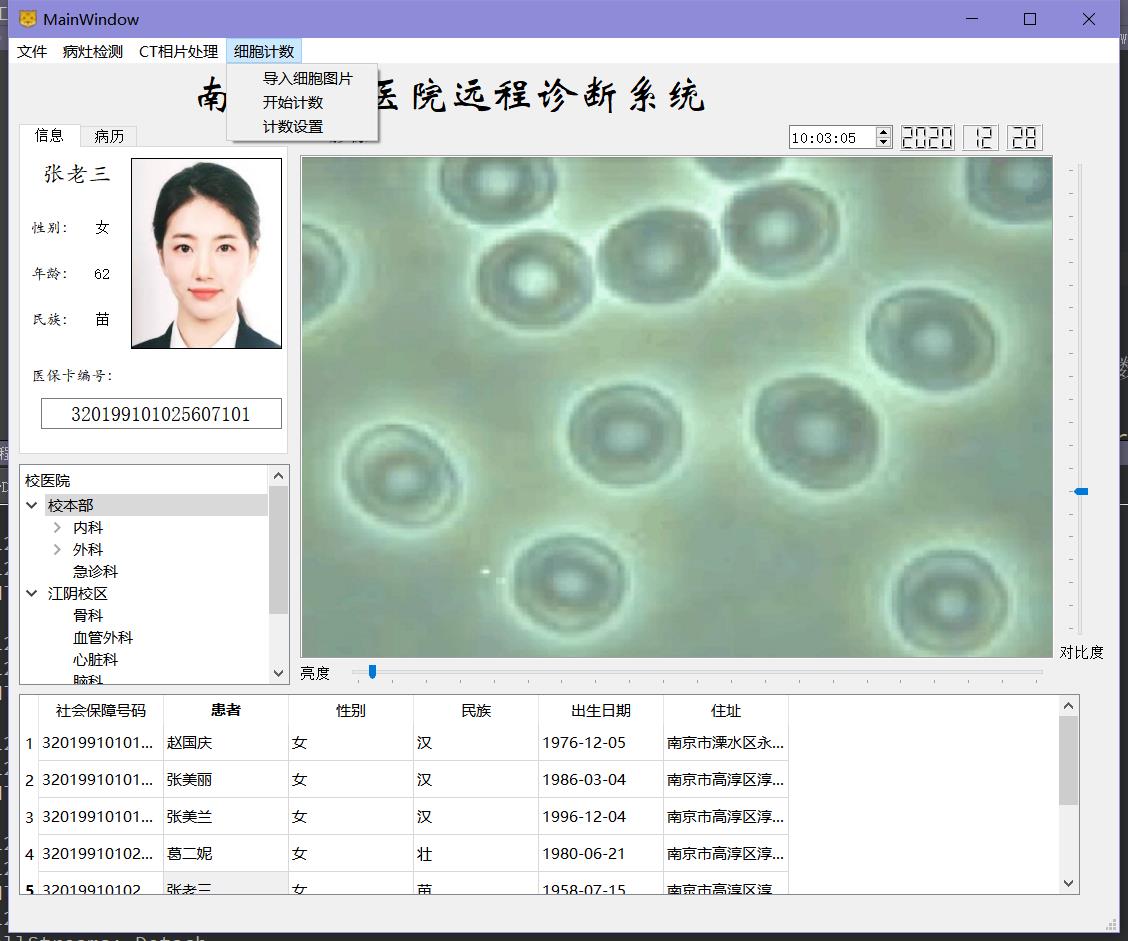

本人研一参考技术书籍开发的一款Qt程序,两年前已上传到GitHub,有兴趣的同学可以去看看。可能之前上传的项目不够完整,导致有一些同学没有在自己的环境上跑通,所以今天将整个工程都重新上传一遍,包括使用到的opencv的动态链接库。
GitHub地址:
https://github.com/luolaihua/TeleMedicine
文章目录
1,使用教程
-
本项目为Qt project, 所以推荐使用Qt Creator工具进行构建,关于Qt 项目的使用,本文不再赘述,请参考其他教程。
-
为了使读者更好的在自己的环境上跑通本项目,这里提供我的Qt以及Qt Creator 版本:
-


-
如果出现找不到libopencv_XXX450.dll的错误,本项目所有依赖的dll都放在TeleMedicine/debug/目录下,需要将所有dll拷贝到exe文件所在目录:

拷贝到编译生成的exe所在的工程目录即可:

2 TeleMedicine
校医院远程诊断系统
医生可使用该软件查看患者的电子档案,通过查看CT相片和化验单等数据,为患者写诊断结果, 同时CT相片经过特定的图像处理算法处理后可以更加凸显病灶,提高医生的诊断效率。
- 使用Qt搭建用户界面,操作数据库以及处理CT相片等图像数据。
- 通过Qt的Model/View架构完成表单与数据库的联动。
- 使用MySQL数据库存储患者的病历档案等信息。
- 使用OpenCV 的图像处理算法完成病灶检测和细胞计数等功能,对CT照片有很好的处理效果。
技术一:OpenCV
病灶检测功能
检测CT相片中的异物,比如肿瘤,将圈出标记。
使用到的技术:opencv中的霍夫圆检测算法
检测流程:
① 读取图像
② 灰度化
③ 高斯滤波,除噪,平滑处理
④ 设置霍夫圆检测算法的参数
⑤ 调用HoughCircles进行圆检测
⑥ 将检测到的圆在原图中标记显示
细胞计数功能
① 读取细胞图片
② 二值化
③ 中值滤波,除噪
④ Canny边缘检测
⑤ 漫水填充算法,颜色填充
⑥ 腐蚀膨胀,进一步除噪
⑦ 使用findContours函数找寻轮廓
⑧ 轮廓数就是细胞个数
⑨ minEnclosingCircle函数寻找包裹轮廓的最小圆
⑩ 将圆在原图中画出显示
细胞计数和病灶检测功能的检测效果依赖于参数的设置,因此设置了参数调节窗口。
CT相片处理
对比度和亮度(convertTo函数)
旋转缩放(放射变化,先生成仿射变换矩阵(getRotationMatrix2D),再对图像进行仿射变换(warpAffine))
滤波除噪(高斯滤波,双边滤波,中值滤波,均值滤波,方框滤波)
阈值处理(threshold函数)
技术二:MySQL数据库
在 5.12 及之前的版本中,Qt 的安装包中自带 MySql 驱动,在 plugins/sqldrivers 目录下可以找到,但到了 5.13 之后,MySql 驱动便没有了,这时我们可以选择手动编译。
下载5.13的源码,手动编译生成dll动态链接库文件,将该文件放入Qt5.13的数据库驱动文件夹中。
Mysql安装流程:
① 下载压缩包,zip文件
② 解压之后设置环境变量,将bin文件夹的路径放入
③ 在安装目录中新建一个ini文件,配置端口(3306)、连接数等等
④ 在bin目录下以管理员的身份打开控制窗口,cmd。输入:mysqld --initialize --console, 初始化,初始化之后,会显示本地主机localhost,管理员root,初始化的随机密码。
⑤ 启动服务:net start mysql
⑥ 登录数据库:mysql -u root -p,输入初始化的密码,
⑦ 修改密码语句:ALTER USER root@localhost INDENTIFIED BY ’123456’
⑧ 删除数据库:musqld --remove mysql
在Qt中使用mysql数据库:
使用QSQLDatabase的方法addDataBase(“QMYSQL”)添加一个mysql数据库,设置主机名,管理员和密码,数据库名称之后,打开数据库
使用QSqlQuery类(exec,prepare,addBindValue)对数据库增删改查,在exec函数中输入sql语句字符串即可操作数据库。
读入图片:使用QFile类将图片读入,保存为QByteArray字节数组,然后将照片数据封装成QVariant变量,在字符串语句中以问号代替数据,然后使用prepare和addBindValue函数,最后执行插入语句exec
使用QSQLTableModel类和QTableView类,模型视图架构。Model加载数据库中的表格或视图(setTable),然后QTableView设置模型(setModel),即可实现表单与数据库的联动
技术三:Qt
设置快捷键:setShortcut,为动作设置快捷键,可以代码添加,也可以在ui文件中添加
事件过滤器:图片双击事件
使用QTreeWidget来显示地区、科室
使用QTabWidget来显示用户信息和病历
使用QTableView来显示病人的表格

本文介绍了一款基于Qt的远程医疗诊断系统,该系统利用OpenCV进行病灶检测和细胞计数,结合MySQL存储患者数据。开发者分享了GitHub上的项目链接,并提供了使用教程,包括OpenCV的图像处理和MySQL数据库的集成方法。
417

被折叠的 条评论
为什么被折叠?



